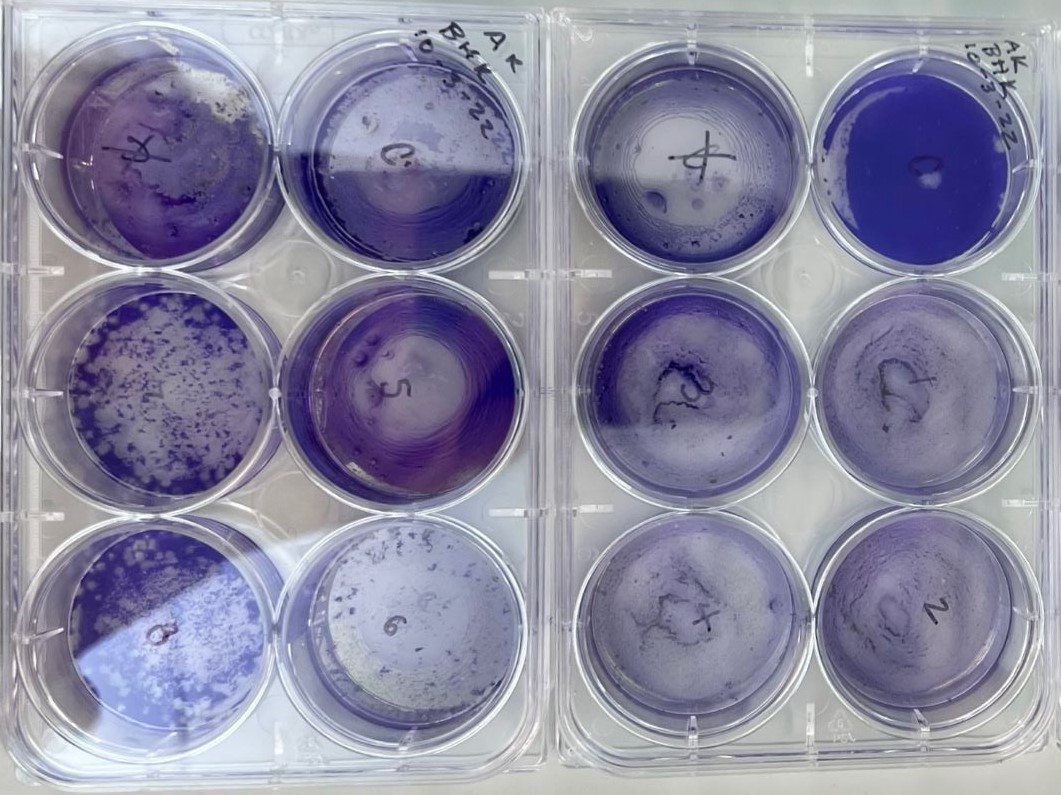

ak
Amanda
is a Scientist
I completed a dual undergraduate degree at The University of Wisconsin Madison in June 2023 majoring in Biochemistry and Chemical Engineering.
“I love Molecular Mechanisms”
Many people don’t exactly know what a molecular mechanism is, but I love them! The more experience I gain working with molecules and their mechanisms the more inspired I become.
As an undergraduate at UW Madison I worked in the Yin Lab developing new experimental and computational methods to better understand how viruses grow and how their infections spread.
As a Junior at UW Madison I worked a 9 month Engineering Co-Op at Hydrite Chemical Co. This work experience guided my intent to pursue a graduate level degree in biochemical research.

ACADEMIA
The University of Michigan’s Program in Biomedical Sciences (PIBS) is where I will continue my studies beginning in July 2023.
After completing my doctorate I aspire to become a University Professor.
RESEARCH
While completing coursework for my PhD I’ll work in a yet-to-be-determined laboratory at the University of Michigan conducting biomedical research. I’m interested in the field of Reproductive Sciences.

FAMILY
My family likes to tease me. They say “academia is my extra-curricular activity”. To be fair, I did beg them to sit and watch me do my Math homework when I was an elementary school student. Nevertheless, I never failed to awe and impress my audience.

DOG DAYS
I have a soft spot for dogs. Ever since I was in middle school a dog has always held a place in my family. Now I can hardly imagine life without one.
This is Ivan the family Standard Schnauzer.

HELLO KITTY
I also love cats! When I was 4 years old Smokey came in to my life. He was the softest kitten ever! I, however, was caught (more than once) sucking on his ear. Come on…I was 4!
I hope to add cats to my family where they will live with a cat-friendly dog and no one will suck on their ears.
It’s been established that therapeutics work, but it’s no longer acceptable for them to only “work good enough”. Future therapeutics need to be great! This will be accomplished as we break down societal barriers from the ground up.
Days Until Grad School Starts
Day(s)
:
Hour(s)
:
Minute(s)
:
Second(s)


